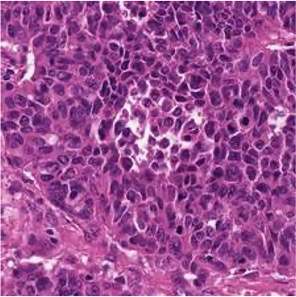
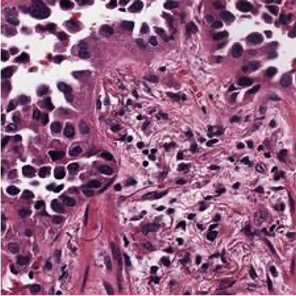
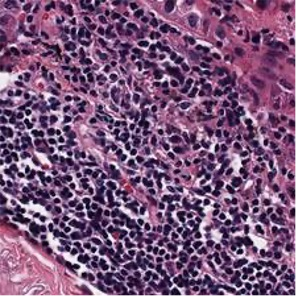
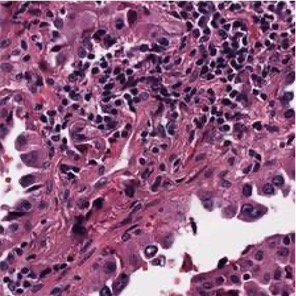
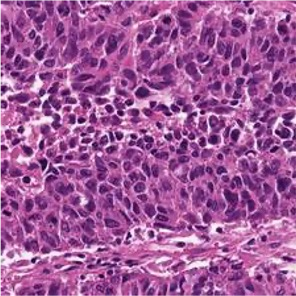
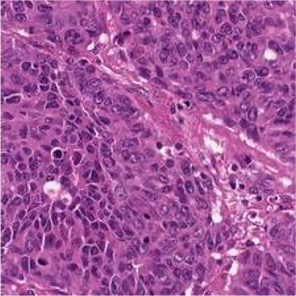
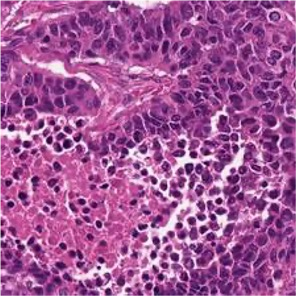

Multiple instance learning (MIL) is a powerful approach to classify whole slide images (WSIs) for diagnostic pathology. A fundamental challenge of MIL on WSI classification is to discover the \textit{critical instances} that trigger the bag label. However, previous methods are primarily designed under the independent and identical distribution hypothesis (\textit{i.i.d}), ignoring either the correlations between instances or heterogeneity of tumours. In this paper, we propose a novel multiplex-detection-based multiple instance learning (MDMIL) to tackle the issues above. Specifically, MDMIL is constructed by the internal query generation module (IQGM) and the multiplex detection module (MDM) and assisted by the memory-based contrastive loss during training. Firstly, IQGM gives the probability of instances and generates the internal query (IQ) for the subsequent MDM by aggregating highly reliable features after the distribution analysis. Secondly, the multiplex-detection cross-attention (MDCA) and multi-head self-attention (MHSA) in MDM cooperate to generate the final representations for the WSI. In this process, the IQ and trainable variational query (VQ) successfully build up the connections between instances and significantly improve the model's robustness toward heterogeneous tumours. At last, to further enforce constraints in the feature space and stabilize the training process, we adopt a memory-based contrastive loss, which is practicable for WSI classification even with a single sample as input in each iteration. We conduct experiments on three computational pathology datasets, e.g., CAMELYON16, TCGA-NSCLC, and TCGA-RCC datasets. The superior accuracy and AUC demonstrate the superiority of our proposed MDMIL over other state-of-the-art methods.
翻译:多重实例学习 (MIL) 是用于诊断病理的全幻灯片图像分类的有力方法。 MIL 在 WSI 分类上的一项基本挑战是发现触发包标签的\ textit{ 关键事件} 。 但是, 先前的方法主要是在独立和相同的分布假设(\ textit{i. id})下设计的, 忽略肿瘤的发生或异质之间的相互关系。 在本文件中, 我们提议采用新型的多克斯检测性多重实例学习( MDMIL) 来解决上述问题。 具体地说, MDMIL 是由内部查询生成模块( IQGM) 和多x检测模块( MDMMIL ) 构建的, 并借助基于记忆的对比性分布式假设(\ textitilitalital) 。 IQGMGM提供实例的概率, 在分布分析后, 集合非常可靠的特性。 第二, 多克斯检测性跨位(MDC) 和多头项自我保存(MHSA) 与MDD(MDA) 合作, 建立内部生成精度的精度精确度(IMDL) 数据, 以生成的精度分析过程, 并测试中, 运行中, 运行中, 运行中, 运行中, 运行中 运行中 运行中 运行中 运行中 运行中 和 运行中 运行中 运行中 运行中 运行中 运行中 运行中 运行中 。